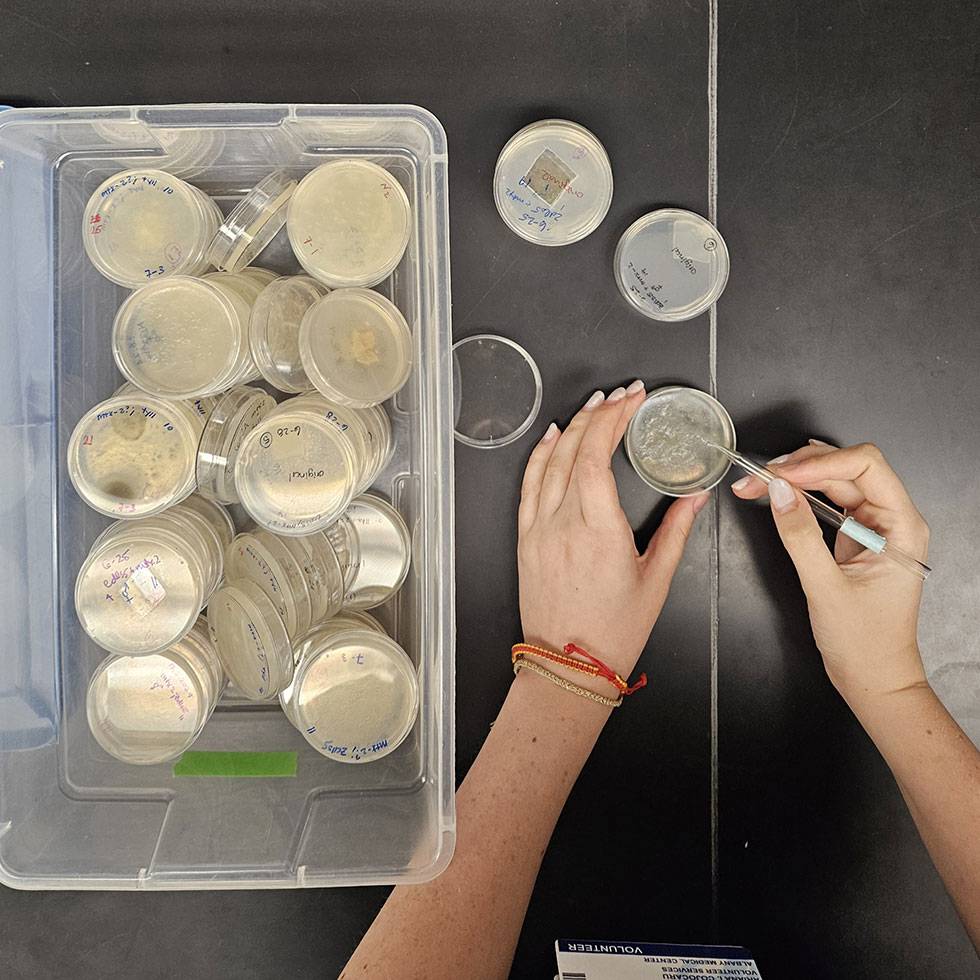
Hands working with petri dishes in a lab setting, examining bacterial cultures using tweezers; a plastic container filled with labeled petri dishes sits nearby on the black lab bench.

Neuroscience
Neuroscience blurs the traditional barriers between specializations like biology, psychology, and chemistry. Study what captures your curiosity — from genetic regulation of circadian rhythms to the impact of cannabinoid use on brain development.
What will you learn?
The Skidmore neuroscience major is anchored by six core lab-based courses in neuroscience, chemistry, biology, and psychology. In choosing your electives, curate a path that fits your interests, whether you want to study on the cellular level or prepare for a career in health care.
Where will you go?
Skidmore neuroscience majors develop intensive and adaptable research and critical-thinking skills that prepare them for graduate school and careers paths including the health professions, research, and clinical work.
| Career paths | Recent employers | Graduate schools |
|---|---|---|
|
|
|
Yes. You will do research.

Research opportunities

Exceptional resources

Summer exploration

What students have to say

Eye-opening summer research
Practical lab experience

Finding her calling
